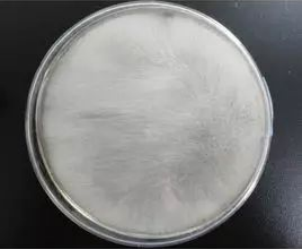

食品生產車間常見霉菌有哪些?污染來源及防治措施呢?
食品加工過程中,“微污染源”有很多,如何防止食品被污染是一項重要課題。霉菌作為微污染源中的一種,如果不加以控制,勢必會影響到食品保質期的長短。
那么,應該如何控制霉菌污染食品呢?
沃特食品檢測專家認為:控制霉菌污染,首先要了解霉菌的生長環境、污染食品的條件。在此基礎上,方可以提出合理的防控措施,提高食品衛生質量。

一、常見的霉菌有哪些呢?
1、曲霉
在自然界中分布廣泛, 它以土壤或空氣為媒介, 可引起食物、谷物和果蔬的霉腐變質,有的可產生致癌性的黃曲霉毒素。該霉在原料貯藏期間幾乎不會死亡。因其對干燥抗性強, 故常在一些干燥食品中被分離出來, 而糖類和殼類處理工廠,也常被此類霉菌污染。烘焙產品中也常因原料,如糖、花生、油、大米等原料帶入曲霉污染。

2、青霉
與曲霉一樣在自然界中廣泛分布, 而且具同樣的生態, 但曲霉生長于中溫至高溫, 而青霉以中溫性為主, 代表種是灰綠青霉,從土壤或空氣中很易分離。青霉的孢子耐熱性較強,菌體繁殖溫度較低,酒石酸、蘋果酸、檸檬酸等烘焙產品常用的酸味劑又是它喜愛的碳源,因而常常引起這些制品的霉變,是干燥性殼物產品處理工廠的主要霉菌。其有害性是造成水果、蔬菜、肉食及衣履腐敗和產生霉菌毒素以及誘發過敏。

3、毛霉
毛霉菌又叫黑霉、長毛霉。毛霉在土壤、糞便、禾草及空氣等環境中存在。在高溫、高濕度以及通風不良的條件下生長良好。在工廠濕度高的環境、通風不良的環境與氣溫差異顯著的地方(如濕的地板和天花板) , 常有此霉菌存在。
4、根霉
黑根霉也稱匐枝根霉,分布廣泛,常出現于生霉的食品上,瓜果蔬菜等在運輸和貯藏中的腐爛及甘薯的軟腐都與其有關。黑根霉是目前發酵工業上常使用的微生物菌種,能糖化淀粉、轉化蔗糖 ,產生乳酸、反丁烯二酸及微量酒精。黑根霉的最適生長溫度約為2~8℃,超過32℃不再生長。

5、交鏈孢霉
交鏈孢霉屬中溫性和好濕性霉菌,易造成腐朽、腐敗和過敏。在高濕度的工廠環境(如糕點、魚肉、水產加工與肉食加工環境) 的天花板、墻與地板、配水管的黑色霉菌, 幾乎為該菌或枝孢霉。
 ?
?
6、鐮刀菌
鐮刀菌是一類世界性分布的真菌,它不僅可以在土壤中越冬越夏,還可侵染多種植物(糧食作物、 經濟作物、藥用植物及觀賞植物),引起植物的根腐、莖腐、莖基腐、花腐和穗腐等多種病害,寄主植物達100余種。本可產生鐮刀菌毒素,食用霉變的糧食可導致人患病和死亡,某些菌種可誘發人皮膚和角膜潰瘍,惡性腫瘤的發生可能與有的菌種有關。

二、霉菌一般需要怎樣的繁殖條件呢?
與霉菌的生長繁殖關系密切的有水分、溫度、基質、通風等條件,為此,只有充分的了解霉菌的生長習性,才能為下一步控制霉菌提供理論依據。
(1) 水分
霉菌生長繁殖首要條件是必須保持一定的水分,大部分霉菌于相對濕度90 %以上, 水含量18 %的高濕度環境下以上容易生長。當食品中的水分活度為0.98時,霉菌最易生長繁殖,當水分活度在0.7以下時,霉菌的繁殖才受到真正的抑制,阻止產毒。所以,水分越高的產品,雖口感會更好,但伴隨著長霉的風險也會更高。
(2) 溫度
溫度對霉菌的繁殖及產毒均有重要的影響,不同種類的霉菌其最適溫度是不一樣的,大多數霉菌繁殖最適宜的溫度為25~30℃,在0℃以下或30℃以上,不能產毒或產毒力減弱。就如黃曲霉的最低繁殖溫度范圍是6-8℃,最高繁殖溫度是44~46℃,最適生長溫度37℃左右,但產毒溫度則不一樣,略低于生長最適溫度,其最適產毒溫度為28-32℃。
(3) 營養基質
與其它微生物生長繁殖的條件一樣,不同的食品基質霉菌生長的情況是不同的,一般而言,營養豐富的食品(如以碳水化合物為主要成分的植物性食品原料)其霉菌生長的可能性就大,天然基質比人工培養基產毒為好。
(4) 氧
霉菌為絕對好氣性微生物, 于通氣良好環境下生長較好, 故厭氧下其生長可被抑制。
三、霉菌污染的來源
不同的食品廠由于加工產品不同, 故污染的霉菌種類也有所差異,但面包、糕點加工廠的霉菌污染源一般來自水、通風良否、操作人員、機械設備、食品原料和包材等。
(1) 面包、糕點加工過程中常產生大量水汽,易造成墻壁潮濕及冷凝水形成的情況 , 容易滋生霉菌。
(2) 一些水槽、水桶、水管、自來水的水龍頭、自來水管、地板與底板等水環境,由于長期貯水,所以污染情形特別常見。如,車間地面、明溝、氣帽有積水潮濕;冷凝水的管路、墻壁、天花板、空調口等;生產過程產生的液體廢棄物未及時清理出車間;離墻離地近的設備表面、潮濕墻面、冷風機容易產生冷凝水滋生霉菌。
(3) 空氣中浮游霉菌的二次污染,如空氣中滋生的霉菌、人員走動時地面揚塵中含有的細菌、空調或新風管道中吹出的霉菌等。
(4) 操作人員自身的二次污染,如手部消毒不徹底、不潔凈衣物手套接觸食品,違反衛生管理制度及不良的衛生習慣,如隨意串崗、不按規定佩戴口罩遮住鼻子、包裝間沒按規定穿連體衣、對著產品說話、打噴嚏、經常抓耳撓腮等等。
(5) 設備、容器的交叉感染,如設備、容器清洗消毒不徹底、不按規定流程定期清洗等、消毒液選用不當或使用劑量不夠等。
(6) 原料帶入的二次污染,可能由于本身質量不過關或者在儲存條件不當受到霉菌污染。
(7) 通過包材的污染,如包裝材料密封性不好,外包裝或包裝袋表面不清潔,附著有微生物,若殺菌不徹底,則其殘留的霉菌素則會直接污染食品。
四、霉菌污染的防治措施
1、控制車間溫濕度
對生產車間霉菌有效控制,首先必須控制車間的溫度和濕度,常開抽濕機及空調,尤其是潮濕天氣,建議車間溫度在24度以下,濕度控制在55%以下,確保車間干爽,因為過高的溫濕度會促進霉菌的生長。同時應設有效的換氣設施,保證車間抽濕機的正常運轉,保證車間內部空氣能夠達到要求指標,空調的換氣程度好壞直接影響到霉菌的產生。如果車間能保證及時將含有大量水份的空氣排出車間,以防止室內溫度過高、蒸汽凝結或異味等發生,大大縮小了可能存在霉菌的可能性。
2、對車間進行空氣消毒
一個細菌及霉菌在24小時內會繁殖成百上千甚至上百萬,包裝間可配上臭氧消毒機、紫外燈(裝在包裝機上方)等。晚上工人下班后,每日車間的空氣殺菌可采用臭氧消毒機和紫外線等同時進行,防止空氣中滋生的微生物累加到白天造成對產品不利,當然,要記得下班后打開, 第二天上班前關閉,消毒期間人員必須撤離哦。在潮濕天氣,建議包裝間每隔2周用甲醛進行徹底的熏蒸消毒。(具體做法可咨詢廣州拜晴技術部)
3、班前、班后工器具注意消毒
酒精噴霧消毒是制造食品時防止霉菌與細菌污染常用的方法, 每天班前、班后對車間內部墻壁、風機、下水道、案面、手部、圍裙套袖、預冷庫和庫門、速凍庫門、包裝室、工器具消毒間使用75%的酒精噴灑消毒,班中每2小時對風機、墻壁、下水道實施75%的酒精噴灑,殺滅霉菌。
4、控制車間內衛生,避免死角位
首先要保持生產車間的內部工具的清潔和衛生,注意對一些衛生死角進行嚴格的衛生清理和保持。每天下班后清洗干凈工器具、設備等,每半月實施一次深度清潔。即管理者與操作人員應具有衛生觀念, 隨時注意操作的衛生與減少 污染的可能性 , 必須從加強員工衛生教育著手。比如,操作案面的背面,天花板、墻壁、空調、制冷風機、抽濕機、干手機等的衛生清理,清理完衛生后所有的墻壁、天棚、設備、器具、案面表面要用酒精擦兩遍以上。請特別注意清理制冷風機的散熱片和冷氣的出風口以及內部電機葉片,這是一個很容易忽視的角落。
5、保證操作人員的清潔衛生
人員的工作服、更衣室等,必須保持衛生清潔,定期清洗和進行紫外線或臭氧殺菌30分鐘以上,防止人為造成霉菌的交叉污染(不可在有人情況下殺菌)。工人每次進入車間前(尤其是冷卻包裝間),先用洗手液洗手,然后換工作服、戴袖套、圍裙、帽子、口罩,然后雙手泡入消毒液(二氧化氯溶液或在超市買家庭用的消毒液稀釋)中5秒,然后直接甩干或用干手機烘干。注意:在消毒液中泡后就不要用布擦干。
6、杜絕車間的污染源,設置潔凈室
在食品工廠內的加熱后放冷至包裝階段,為最需防止外部浮游菌侵入和落菌的污染,有條件者可以設置潔凈室,利用空氣導入設施,將可達到空氣潔凈化, 減少污染的目的。同時,請注意以下細節:對于制造環境的天花板、壁面與地板等, 為防止霉菌污染,車間的一切用具包括裝修所用的材料盡量使用塑料、不銹鋼等易清洗、防腐蝕、抗霉菌與防止結露的材料,盡量避免使用木頭、鐵等材料,因為木頭遇水濕潤后易長霉點,鐵材質易生銹脫落影響產品質量。另外,冷卻包裝間內不得存放紙皮、木頭、臟毛巾、窗簾掃把、拖把等容易藏污納垢的物品,原料外包裝物應拆除后再傳送進冷卻間,以避免污染產品。